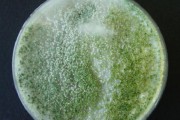

โดย monmai

ถ่านอัดแท่ง(แบบอัดเย็น) พลังงานทางเลือกคุณภาพสูง
ถ่านอัดแท่ง เป็นถ่านที่ทำจากวัสดุเหลือใช้จากธรรมชาติ ซึ่งเป็นกะลามะพร้าว หรือแกลบและสามารถนำมาทดแทนถ่านไม้ธรรมชาติได้ ซึ่งเป็นการรักษาสิ่งแวดล้อม ...

เกษตรกรรมยั่งยืน วิถีแห่งความยั่งยืน
เกษตรกรรมยั่งยืน เป็นวิถีเกษตรกรรมที่ฟื้นฟูทรัพยากรธรรมชาติและดำรงรักษาไว้ซึ่งความสมดุลของระบบนิเวศ สามารถผลิตอาหารที่มีคุณภาพและพอเพียงตามความจำเป็นพื้นฐาน ...

รางจืด สมุนไพรล้างพิษ
รางจืด เป็นสมุนไพรไทยที่ได้รับการยืนยันทางวิทยาศาสตร์ว่า มีสรรพคุณ แก้ท้องร่วง อาการแพ้ ผื่นคัน แก้พิษยาฆ่าแมลงในสัตว์ แก้พิษจากสารในยา กำจัดศัตรูพืช แก้พิษเคมี พิษเบื่อเมา ...

แม่ทา บทเรียนที่ยาวนานสู่การพัฒนาที่ยั่งยืน
ชุมชนตำบลแม่ทา สันนิฐานว่าอพยพมาเมื่อปี พ.ศ. 2186 โดยมีชนเผ่ายางแดง ซึ่งเป็นชาวปากาเกอญอ เข้ามาอยู่ที่ห้วยยางคา ...

ตำลึง ผักสวนครัวรั้วกินได้
ตำลึง เป็นผักพื้นบ้านที่คนทั่วไปรู้จักกันมานาน เป็นผักที่มี คุณค่าทางโภชนาการมาก สามารถนำไปปรุงอาหารได้หลากหลายชนิด เช่น แกงจืด ต้มจิ้มน้ำพริก ใส่ก๋วยเตี๋ยวและต้มเลือดหมู ...

กังหันนาเกลือ นวัตกรรมกังหันลมของไทย
ลมเป็นปรากฏการณ์ทางธรรมชาติ ซึ่งเกิดจากความแตกต่างของอุณหภูมิ ความกดดันของบรรยากาศและแรงจากการหมุนของโลก สิ่งเหล่านี้เป็นปัจจัยที่ก่อให้เกิดความเร็วลมและกำลังลม ...

เห็ดฟาง อาหารสุขภาพของคนความดันสูง
เห็ดฟางเป็นเห็ดยอดนิยมของคนไทย นิยมเพาะกันบนกองฟางข้าวชื้นๆ โคนมีสีขาว ส่วนหมวกสีน้ำตาลอมเทา หาซื้อได้ง่ายตามท้องตลาดตลอดทั้งปีเดิมคนไทยเรียกเห็ดฟางว่า เห็ดบัว ...

เทคโนโลยีสรรพสิ่งอะตอมมิคนาโน
นวัตกรรมเทคโนโลยีสรรพสิ่งอะตอมมิคนาโน คือการทำปุ๋ยอินทรีย์ที่เป็นเทคโนโลยีสร้างพฤติกรรมจุลินทรีย์ใหม่ ที่สามารถขยายพันธุ์ด้วยตนเองโดยการให้อาหารแก่จุลินทรีย์ ...

พัฒน์ อภัยมูล ปราชญ์แห่งลุ่มน้ำแม่ทา
นายพัฒน์ แกนนำเกษตรยั่งยืน ของบ้านแม่ทา เป็นคนแรกที่ปรับเปลี่ยนวิถีการทำเกษตรเชิงเดี่ยวเพื่อการขายมาสู่วิถีการเกษตรแบบยั่งยืน มีจุดเริ่มต้นในการเปลี่ยนแปลง ในช่วงปี 2529 ...

ไผ่ ไม้สารพัดประโยชน์
ไผ่เป็นพืชใบเลี้ยงเดี่ยวอยู่ในวงศ์ Gramineae เช่นเดียวกับหญ้าแต่เป็นพืชตระกูลหญ้าที่สูงที่สุดในโลก เป็นไม้พุ่มหลายชนิดและหลายสกุลใน วงศ์หญ้า Poaceae (เดิมคือ Gramineae) วงศ์ย่อย Bambusoideae ...

นวดแผนไทย มรดกภูมิปัญญาแพทย์แผนไทย
การนวดแผนไทย หรือ นวดแผนโบราณ เป็นการนวดชนิดหนึ่งในแบบไทย ซึ่งเป็นศาสตร์บำบัดและรักษาโรคแขนงหนึ่งของการแพทย์แผนไทย โดยจะเน้นในลักษณะการยืดเส้น และการกดจุด ...

เพาะเห็ดฟางในตะกร้า
ปกติเห็ดฟาง เป็นเห็ดที่เกิดขึ้นเองตามธรรมชาติได้ง่ายแต่ด้วยจะรอธรรมชาติอย่างเดียวคง ไม่พอกับความต้องการที่จะบริโภคของมนุษย์ ...
ไตรโคเดอร์มา เชื้อรามหัศจรรย์สำหรับใช้ควบคุมโรคพืช
เชื้อราไตรโคเดอร์มา เป็นเชื้อราชั้นสูงที่ดำรงชีวิตอยู่ในดิน อาศัยเศษซากพืช ซากสัตว์และอินทรียวัตถุเป็นแหล่งอาหาร เจริญได้รวดเร็วบนอาหารเลี้ยงเชื้อราหลายชนิด ...

บัวบก สมุนไพรแก้ช้ำใน
บัวบก เป็นสมุนไพรในเขตร้อนที่ขึ้นในที่ชื้นๆ ทั่วไป เป็นผักพื้นบ้านที่คนในแถบนี้คุ้นเคย ในพม่ามียำใบบัวบก คนมาเลเซียผสมใบบัวบกลงในผักสลัด ในไทยนิยมใช้บัวบกเป็นผักแกล้มลาบ ...

พริก พืชรสเผ็ดรสชาติแบบไทย
พริกเป็นพืชผักที่มีความสำคัญในการประกอบอาหารประจำวัน สำหรับคนไทยเป็นอย่างมาก เนื่องจากคนไทยนิยมรับประทานอาหารที่มีรสชาติค่อนข้างเผ็ด ...

